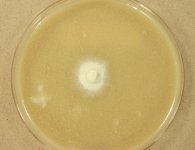

Search Details
| UAMH Number: | 11491 |
|---|---|
| Species Name: | Endoxyla macrostoma |
| Type: | |
| Synonyms: | |
| Taxonomy: | FUNGI Ascomycota, Sordariomycetes, Boliniales, Boliniaceae |
| Strain History: | Untereiner, W. (WUC 679) -> UAMH |
| Substrate: | rotting decorticated wood of Pinus strobus | Location: | CANADA Prince Edward Island, Queens County, Brookvale Demonstration Woodlot (GEO: 46.298,-63.408) |
| Isolator: | (C) A. Carter; (I) W. Untereiner |
| Isolation Date: | 2009-06-01 |
| Date Received: | 2011-03-31 |
| Characters: | CULTURE CONDITIONS does not sporulate in culture - fide W. Untereiner // MOLECULAR SYSTEMATICS systematics of Apiorhynchostoma, Endoxyla and Pseudovalsaria in the Boliniales - Untereiner WA, Bogale W, Carter A, Platt HW, Hanson S-A, T Laessoe, Stepanek V, Reblova M, Mycologia 105:564-588, 2013 // ODOR/ ODOUR fruity - fide UAMH 2012 (Click for publications citing UAMH 11491) |
| Compounds: | |
| Cross Reference: | |
| Collections: | Living Strains; Dried Herbarium Material |
| Pathogenic Potential: | Human: no | Animal: no | Plant: no |
| Biosafety Risk Group: | RG1 (check the PHAC ePATHogen Risk Group Database for updates) |
| Regulatory Requirements: | No restrictions for Canadian requesters. International requesters must provide all legally required importation documentation prior to shipment. Plant pathogenicity status may be verified by using the USDA Agricultural Research Service (ARS) Fungal Database |
| MycoBank ID: | 165617 |
| Sequences: | >UAMH11491_NR120208 CAAAATCGTTGAGTTGCGAGACTCGAAAACCATCGCGAACATACCTTGTCGTTGCTTCGGCGGGCGGCCCCCAGTCTGGGGCGCCTCGGGACGCCGTAGCCCGAGAGGGCGCCCGCCGGAGGACCTACCAAAATCACCTCTGTTTCCTCGCGTCTCTCTGAGTTTGACTAGCGAATTTACGTTAAAACTTTCAACAACGGATCTCTTGGTTCTGGCATCGATGAAGAACGCAGCGAAATGCGATAAGTAATGTGAATTGCAGAATTCAGTGAATCATCGAATCTTTGAACGCACATTGCGCCCGCCAGCATTCTGGCGGGCATGCCTGTTCGAGCGTCATTTCGACCCCTCAAGCCCCTCCGGCTTGGTGTTGGGGCTCCCTACGTTCGCCGTAGGCCCCGAATTCTAGTGGCGGGCTCGCCGTAATCCCGAGCGTAGTAGTGTTACCTCGCTCAGGGCGCGCGGCGGGCGCCGGCCGTGAAAACAAAACCCACACAGAAGG >UAMH11491_JX460985_ITS CAAAATCGTTGAGTTGCGAGACTCGAAAACCATCGCGAACATACCTTGTCGTTGCTTCGGCGGGCGGCCCCCAGTCTGGGGCGCCTCGGGACGCCGTAGCCCGAGAGGGCGCCCGCCGGAGGACCTACCAAAATCACCTCTGTTTCCTCGCGTCTCTCTGAGTTTGACTAGCGAATTTACGTTAAAACTTTCAACAACGGATCTCTTGGTTCTGGCATCGATGAAGAACGCAGCGAAATGCGATAAGTAATGTGAATTGCAGAATTCAGTGAATCATCGAATCTTTGAACGCACATTGCGCCCGCCAGCATTCTGGCGGGCATGCCTGTTCGAGCGTCATTTCGACCCCTCAAGCCCCTCCGGCTTGGTGTTGGGGCTCCCTACGTTCGCCGTAGGCCCCGAATTCTAGTGGCGGGCTCGCCGTAATCCCGAGCGTAGTAGTGTTACCTCGCTCAGGGCGCGCGGCGGGCGCCGGCCGTGAAAACAAAACCCACACAGAAGG >UAMH11491_JX460990_LSU TTGACCTCGGATCAGGTAGGAATACCCGCTGAACTTAAGCATATCAATAAGCGGAGGAAAAGAAACCAACAGGGATTGCCCCAGTAACGGCGAGTGAAGCGGCAACAGCTCAAATTTGAAATCCGGCTTCGGCCCGAGTTGTAATTTGCAGAGGATGCTTTTGGCGCGGCGCCTCCCGAGTCCCCTGGAACGGGGCGCCACAGAGGGTGAGAGCCCCGTATGGTAGGACGCCTAGCCTGTGTAAAGCTCCTTCGACGAGTCGAGTAGTTTGGGAATGCTGCTCAAAATGGGAGGTAAATTCCTTCTAAAGCTAAATACCGGCCAGAGACCGATAGCGCACAAGTAGAGTGATCGAAAGATGAAAAGTACTTTGAAAAGAGGGTTAAACAGCACGTGAAATTGTTGAAAGGGAAGCGCTCGTGACCAGACTTGCGCCGGGTCGATCATCTGGTGTTCTCACCGGTGCACTCGGCCCGGTTCAGGCCAGCATCGGTTCTCGCGGGGGGATAAAAGCCCTGGGAACGTAGCTCCTCCGGGAGTGTTATAGCCCTGGGCACAATACCCTCGCGGGGACCGAGGCCCGCGCTCTGCAAGGATGCTGGCGTAATGGTCACCAGCGACCCGTCTTGAAACACGGACCAAGGAGTCAAGGTTTTGCGCGAGTGTTTGGGTGTAAAACCCGCACGCGTAATGAAAGTGAACGTAGGTGAGAGCTTCGGCGCATCATCGACCGATCCTGATGTTCTCGGACGGATTTGAGTAAGAGCGTAATGCCTTGGACCCGAAAGATGGTGAACTATGCCTGGATAGGGTGAAGCCAGAGGAAACTCTGGTGGAGGCTCGCAGCGGTTCTGACGTGCAAATCGATCGTCAAATCAGGGCATGGGGGCGAAAGACTAATCGAACCATCTAGTAGCTGGTTACCGCCGAAGTTTCCCTCAGGATAGCAGTGTTGATCTTCAGTTTTATGAGGTAAAGCGAATGATTAGGGACTCGGGGGCGCTATTTTGCCTTCATCCATTCTCAAACTTTAAATATGTAAGAAGCCCTTGTTACTTGGCTGAACGTGGGCATTCGAATGTACCAACACTAGTGGGCCATTTTTGGTAAGCAGAACTGGCGATGCGGGATGAACCGAACGCGGGGTTAAGGTGCCGGAGTGGACGCTCATCAGACACCA >UAMH11491_NG042716_LSU TTGACCTCGGATCAGGTAGGAATACCCGCTGAACTTAAGCATATCAATAAGCGGAGGAAAAGAAACCAACAGGGATTGCCCCAGTAACGGCGAGTGAAGCGGCAACAGCTCAAATTTGAAATCCGGCTTCGGCCCGAGTTGTAATTTGCAGAGGATGCTTTTGGCGCGGCGCCTCCCGAGTCCCCTGGAACGGGGCGCCACAGAGGGTGAGAGCCCCGTATGGTAGGACGCCTAGCCTGTGTAAAGCTCCTTCGACGAGTCGAGTAGTTTGGGAATGCTGCTCAAAATGGGAGGTAAATTCCTTCTAAAGCTAAATACCGGCCAGAGACCGATAGCGCACAAGTAGAGTGATCGAAAGATGAAAAGTACTTTGAAAAGAGGGTTAAACAGCACGTGAAATTGTTGAAAGGGAAGCGCTCGTGACCAGACTTGCGCCGGGTCGATCATCTGGTGTTCTCACCGGTGCACTCGGCCCGGTTCAGGCCAGCATCGGTTCTCGCGGGGGGATAAAAGCCCTGGGAACGTAGCTCCTCCGGGAGTGTTATAGCCCTGGGCACAATACCCTCGCGGGGACCGAGGCCCGCGCTCTGCAAGGATGCTGGCGTAATGGTCACCAGCGACCCGTCTTGAAACACGGACCAAGGAGTCAAGGTTTTGCGCGAGTGTTTGGGTGTAAAACCCGCACGCGTAATGAAAGTGAACGTAGGTGAGAGCTTCGGCGCATCATCGACCGATCCTGATGTTCTCGGACGGATTTGAGTAAGAGCGTAATGCCTTGGACCCGAAAGATGGTGAACTATGCCTGGATAGGGTGAAGCCAGAGGAAACTCTGGTGGAGGCTCGCAGCGGTTCTGACGTGCAAATCGATCGTCAAATCAGGGCATGGGGGCGAAAGACTAATCGAACCATCTAGTAGCTGGTTACCGCCGAAGTTTCCCTCAGGATAGCAGTGTTGATCTTCAGTTTTATGAGGTAAAGCGAATGATTAGGGACTCGGGGGCGCTATTTTGCCTTCATCCATTCTCAAACTTTAAATATGTAAGAAGCCCTTGTTACTTGGCTGAACGTGGGCATTCGAATGTACCAACACTAGTGGGCCATTTTTGGTAAGCAGAACTGGCGATGCGGGATGAACCGAACGCGGGGTTAAGGTGCCGGAGTGGACGCTCATCAGACACCA |
IMAGES: